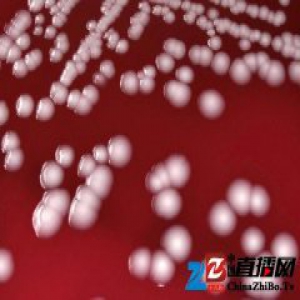
世卫组织表示，致命耐药的“超级细菌”对人类构成巨大威胁

2017-03-01 15:51:18

2017-03-01 15:49:49

2017-03-01 15:48:54
2017-03-01 15:48:10

Moncler销售额超 10 亿,以及,耐克气垫工厂首次曝光 | 浮华日报
2017-03-01 15:47:35

2017-03-01 15:47:04

2017-03-01 15:46:18

2017-03-01 15:45:46

2017-03-01 15:44:53

「这世界」想住在核控制中心里吗?买下只有不到 25 万美元哦
2017-03-01 15:44:11